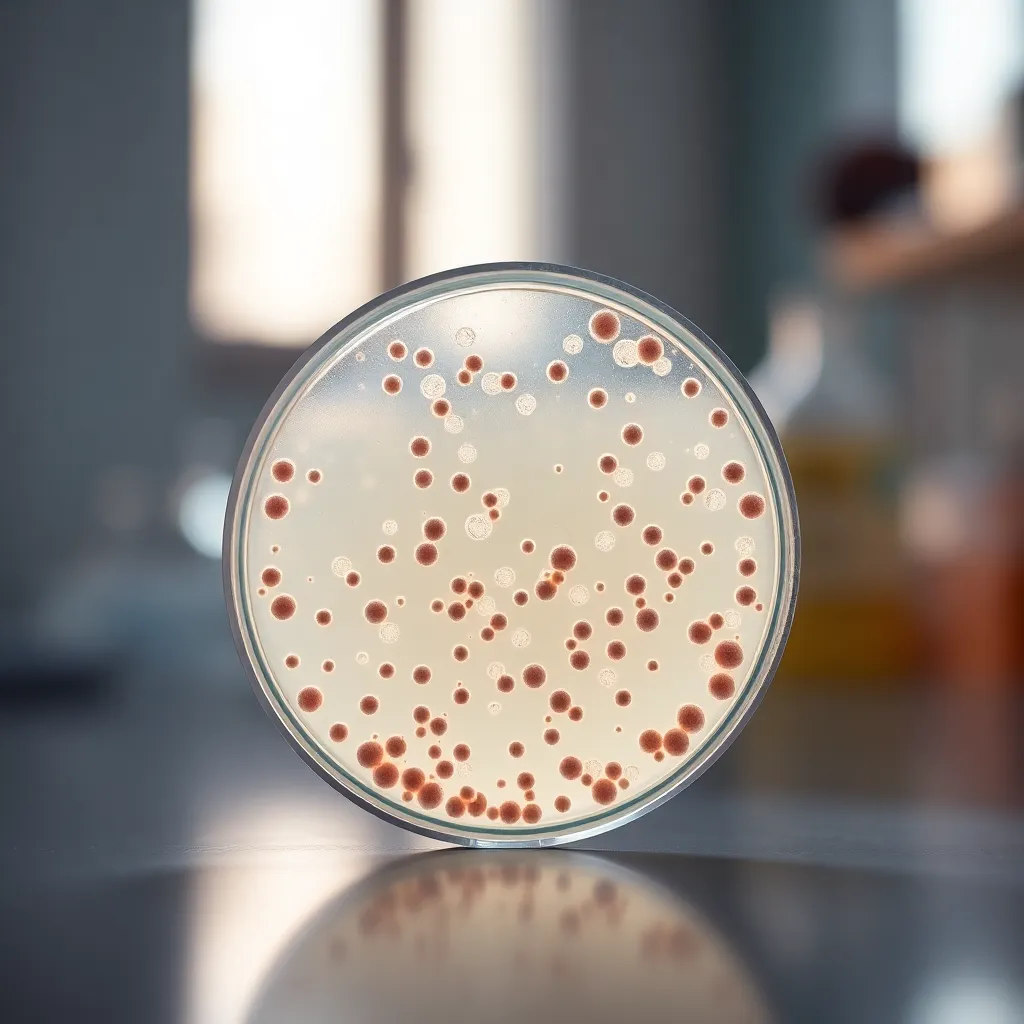
Petri Dish with Bacterial Cultures

Related Tags

Scientist Using Microscope in Laboratory

Researcher Holding Test Tube in Laboratory

Late-Night Laboratory Experiment Setup

Collaborative Science Team Analyzing Data

Dynamic Laboratory Research Scene with Scientists

Scientist Analyzing Bacteria in Laboratory

Scientist in Modern Laboratory

Biochemist Analyzing Microscope Slide

Female Scientist Working in a Laboratory

Intricate Glass Microscope in Laboratory

Astronaut Conducting Research in Space Habitat

DNA Strand on Laboratory Table

Astronaut Researching on Mars

Researcher Analyzing DNA Sequence

Scientists Collaborating in High-Tech Laboratory

Dedicated Scientist Analyzing Cultures

Astronauts Conducting Research in Lunar Base

Astronauts Conducting Experiments in Space Lab

Astronauts Conducting Research on the Lunar Surface

Astronauts in High-Tech Spacecraft Lab

Mars Base at Sunrise with Astronauts Conducting Research

Astronauts Conducting Research on the Moon

Astronaut Researching Alien Flora

Astronaut Conducting Experiments in ISS Lab

Astronaut Conducting Experiment in Space Laboratory

Astronaut Conducting Research Inside Spacecraft

Astronaut Conducting Research in Martian Habitat

Astronaut Analyzing Data in Habitat

Astronaut Conducting Experiments in Space Habitat

Close-Up of DNA in Petri Dish

Scientist Working With DNA Model

Scientist Analyzing DNA Structure

Scientist Using Pipette in Modern Laboratory

Lab Technician Examining Samples Under Microscope

Astronauts Conducting Research on the Moon

Microscope Under Natural Light in Laboratory

Scientist Analyzing Petri Dish in Laboratory

Astronaut in Zero-Gravity with Scientific Equipment

Futuristic Space Habitat and Astronauts

Astronaut Conducting Experiments in Spacecraft

Astronauts in Science Lab Aboard Spacecraft

Astronaut Conducting Research on Mars

Astronauts Conducting Research on the Moon

Mars Model in Scientific Laboratory

Astronaut Conducting Research in Space Lab
Petri Dish with Bacterial Cultures

Laboratory Glassware in Natural Light

Modern Digital Microscope in Laboratory

Stack of Scientific Journals in Laboratory

Wide View of Modern Laboratory Workspace

Astronauts Collaborating in Space Station Research Lab

Astronaut Conducting Lab Experiments

Astronaut Conducting Research in Space Habitat

Scientist Analyzing Test Tube in Laboratory

Microscope on Laboratory Table with Natural Light

Scientist Analyzing Bacterial Cultures

Scientist Analyzing Digital DNA Data

Scientist Analyzing DNA Sequence

Chemist Analyzing Sample in Laboratory

Microscope and Equipment in Laboratory

Scientist Analyzing DNA Sequencing Chip

Scientist Analyzing DNA Sequencer

Modern Laboratory Setup with Scientific Equipment

Scientist Working in a Modern Lab

Intricate Laboratory Equipment Setup

Close-Up of a Laboratory Microscope

Astronaut Researching on Alien Planet

Colorful Laboratory Reagents Display

Astronauts Conducting Experiments on Mars

Scientist Examining Slide Under Microscope

Scientist Examining Petri Dish in Laboratory

Microbiologist Working in the Lab

Scientist Examining Samples in Laboratory

Scientist Analyzing DNA Sequences

Lush Fern in a Modern Biology Lab

Scientific Exploration with Petri Dishes

Biologist Analyzing Petri Dish Under Warm Light

Scientist Analyzing Microbial Cultures in Lab

Scientist Examining DNA Structure Model

Illuminated DNA Strands Close-Up

Scientist Handling DNA Samples in Lab

Biologist Analyzing Samples in Laboratory

Astronauts Conducting Research on the Moon

Astronaut Conducting Experiment in Space Station

Scientist Examining Soil Samples

Focused Female Scientist Analyzing Samples in Lab

Dedicated Scientist Analyzing Specimen in Laboratory

Scientist in Laboratory

Astronauts Researching on an Exoplanet

Astronauts Working in Lunar Research Base

Conducting Experiments in Space

Astronaut Analyzing Lunar Rocks

Astronauts Conducting Experiment on Lunar Base

Astronauts Research on Mars Surface

Astronaut Conducting Experiment Inside ISS

Astronauts Exploring Alien Flora

Astronauts Researching on Martian Landscape

Astronauts Researching on the Moon

Astronauts Conducting Research on Mars at Sunrise

Astronaut Conducting Research in Space

Astronaut Nurturing Life in Space

Astronaut Conducting Experiments on Mars

Astronauts Researching on Mars

Astronaut Researching on Mars

Astronaut Researching in Space Habitat

Astronauts Conducting Research in Space Habitat

Astronaut Team Conducting Research Inside Spacecraft

Astronauts Researching in Space Laboratory

Astronaut Conducting Experiment Inside Space Capsule

Astronaut Researching on Moon Surface

Astronaut Conducting Experiment in Space Habitat

Astronaut Conducting Experiments in Spacecraft

Astronaut Conducting Research Inside Space Habitat

Astronauts Conducting Research on Mars

Astronaut Conducting Research in Space Station

Astronauts Conducting Research on Lunar Surface

Astronaut Researching Mars Landscape

Astronaut Conducting Research in Habitat Module

Astronauts Conducting Research on the Moon

Astronauts Researching in Spacecraft

Astronaut Conducting Experiments in Space Habitat

Astronaut Researching on Mars Surface

Female Astronaut in Space Laboratory

Astronaut Conducting Experiment in Space Station

Astronauts Researching on the Moon

Astronauts Researching in Martian Landscape

Astronauts Researching at Lunar Base

Astronaut Conducting Research in Space

Astronauts Working in Mars Habitat

Astronauts Research Experiment on Moon

Astronauts Conducting Research in Space Station

Close-Up of Microscope in Laboratory Setting

Microbiologist Analyzing Petri Dishes in Laboratory

Researcher Analyzing Samples in Modern Lab

Scientist Examining Samples in Laboratory

Laboratory Scene with Vibrant Blue Liquid

Scientist at Work in Laboratory

Scientist Analyzing Holographic Data

Scientist Examining Petri Dish in Laboratory

High-Tech Laboratory Equipment and Setup

Chemist at Work in the Lab

Laboratory Scene with Scientific Equipment

Scientist Analyzing Samples Under Microscope

Scientist Conducting Experiment in Modern Lab

Modern Library Study Group in Action

Scientist Analyzing DNA Sequencing

Pharmaceutical Research in Modern Laboratory

Lab Technician Analyzing Bacterial Cultures

Scientist Working in Bright Laboratory

Evening in a High-Tech Laboratory

Scientific Research in DNA Analysis

Chemist Analyzing Molecular Model

Scientist Examining Samples Under Microscope

Collaborative Research on DNA Sequences

Vibrant Specimen on Glass Slide

Intricate Cellular Structures Under Microscope

Intricate Physics Experiments in Laboratory

Technician Analyzing Sample in Laboratory